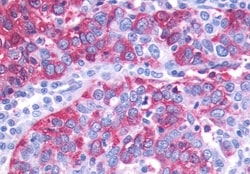
Invitrogen GPR143 Polyclonal Antibody 50 &mu;g; Unconjugated:Antibodies,

missing translation for 'onlineSavingsMsg'
Learn More
Learn More
Invitrogen™ GPR143 Polyclonal Antibody


Rabbit Polyclonal Antibody
Brand: Invitrogen™ PA533634
This item is not returnable.
View return policy
Description
Percent identity with other species by BLAST analysis: Human, Gorilla (100%) Monkey, Marmoset (88%).
Ocular albinism type 1 protein is a conserved integral membrane protein with seven transmembrane domains. It is expressed in the eye and epidermal melanocytes. Defects in GPR143 are the cause of ocular albinism type 1 (OA1); also known as Nettleship-Falls type ocular albinism. OA1 is an X-linked disorder characterized by severe impairment of visual acuity, retinal hypopigmentation and the presence of macromelanosomes.
Specifications
| GPR143 | |
| Polyclonal | |
| Unconjugated | |
| GPR143 | |
| G protein-coupled receptor 143; GPR143; G-protein coupled receptor 143; homolog of human ocular albinism 1 (Nettleship-Falls); MOA1; NYS6; OA1; ocular albinism 1; ocular albinism type 1 protein; Ocular albinism type 1 protein homolog; RGD1565799 | |
| Rabbit | |
| Antigen Affinity Chromatography | |
| RUO | |
| 4935 | |
| Store at 4°C short term. For long term storage, store at -20°C, avoiding freeze/thaw cycles. | |
| Liquid |
| Immunohistochemistry (Paraffin) | |
| 1 mg/mL | |
| PBS with 0.1% sodium azide | |
| P51810 | |
| GPR143 | |
| Synthetic 16 amino acid peptide from C-terminus of human GPR143. | |
| 50 μg | |
| Primary | |
| Human | |
| Antibody | |
| IgG |
Product Content Correction
Your input is important to us. Please complete this form to provide feedback related to the content on this product.
Product Title
Spot an opportunity for improvement?Share a Content Correction